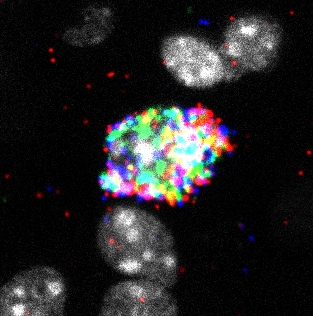
Fluorescent microscopy image showing Pthlh interneurons in brain tissue with multicolor immunofluorescence staining

Our Research
Exploring the complexities of the brain through innovative research approaches
Our group aims to discern the main genetic pathways affected in Parkinson's disease and other neurodegenerative disorders. To this end, we use single-cell RNA sequencing, which will allow us to describe the main genetic alterations with cell-type specificity, using both postmortem brain tissue from patients, cells from peripheral fluid samples donated by patients, and tissue from animal models.
Data will be validated using histological techniques such as immunofluorescence and in situ hybridization, and spatial transcriptomics techniques such as in situ sequencing. The high sensitivity of the techniques used will allow us to determine the most affected cell types and most involved genes, which will lead to the exploration of new therapeutic targets and treatment pathways.
Deciphering the role of the Pthlh interneuron population in the development of neurodegenerative diseases
In our laboratory we have developed a new transgenic mouse line consisting of a knock-in that expresses the cre recombinase protein under the Pthlh promoter. This mouse line allows us to study in depth the recently described Pthlh striatal interneurons, their role in the basal ganglia circuitry and in the development of neurodegenerative diseases.
Key research areas include:
- Histological and electrophysiological characterisation of Pthlh interneurons.
- Chemogenetic manipulation of these interneurons to study their involvement in motor and cognitive functions.
- The study of the cell comunication in the local circuitry of the striatum and other brain areas with striatal Pthlh interneurons.

Neuron Type-Specific Transcriptomic Alterations in the Human Parkinsonian Striatum
We use single‑nucleus RNA sequencing (snRNA-seq) of dorsal striatal neurons from Parkinson's disease and control brains, combined with in situ sequencing, to define cell‑type–specific transcriptomic changes, map their spatial distribution, and identify molecular drivers of neuronal vulnerability.
Key research areas include:
- Unsupervised clustering of snRNA-seq data to define and classify neuronal subtypes in human postmortem tissue.
- Identification gene expression changes and molecular traits linked to neuronal vulnerability in Parkinson's disease.
- Integration of spatial data via In Situ Sequencing (ISS) to localize transcriptomic alterations within the anatomical context of the striatum.
Regulatory Gene Networks in Parkinson's Disease
We apply single-cell and spatial transcriptomics to study the role of glial cells in Parkinson's disease, focusing on the striatum—a brain region essential for motor control. By integrating data from both techniques, we aim to uncover key genetic alterations, disrupted molecular pathways, disease-associated glial subtypes, and changes in the cellular composition of oligodendrocytes, OPCs, astrocytes, microglia, and vascular and immune cells.
Key research areas include:
- Identifying PD-associated shifts in gene expression at high resolution
- Inferring dysregulated molecular pathways and upstream regulators involved in glial dysfunction.
- Integrating in situ spatial data to uncover regional expression patterns and glial interactions in affected brain tissue.
